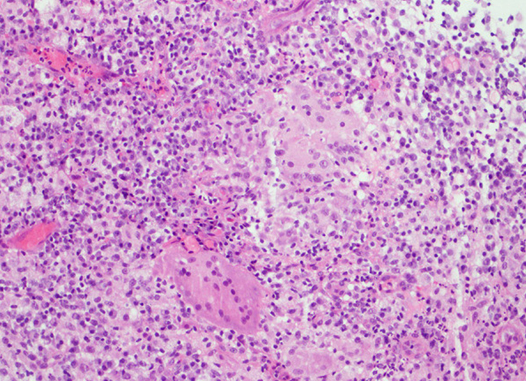
Ιστολογική εικόνα μη τυροποιητικών κοκκιωμάτων (Ευγενική παραχώρηση Dr. V. Penopoulos)
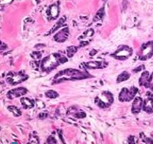
Ψηφιακή μαστογραφία. Θηλώδες καρκίνωμα ανδρικού μαστού (Ευγενική παραχώρηση Dr. V. Penopoulos)

Μαστός
55 εικόνες
Ιστολογική εικόνα μη τυροποιητικών κοκκιωμάτων (Ευγενική παραχώρηση Dr. V. Penopoulos)

PET scan. Εμφανής η υπερμεταβολική εστία στον δεξιό μαστό (Ευγενική παραχώρηση Dr. V. Penopoulos)

PET scan. Εμφανής η υπερμεταβολική εστία στον δεξιό μαστό (Ευγενική παραχώρηση Dr. V. Penopoulos)

PET scan. Εμφανής η υπερμεταβολική εστία στον δεξιό μαστό (Ευγενική παραχώρηση Dr. V. Penopoulos)

MRI μαστογραφία. Ετερογενής ενισχυμένη πρόσληψη γαδολινίου στον δεξιό μαστό (Ευγενική παραχώρηση Dr. V. Penopoulos)

CT θώρακα. Παρουσία μεγάλης, ακανόνιστης μάζας στο δεξιό μαστό (Ευγενική παραχώρηση Dr. V. Penopoulos)

Ψηφιακή μαστογραφία. Παρουσία μάζας υψηλής πυκνότητας, ακανόνιστου σχήματος (Ευγενική παραχώρηση Dr. V. Penopoulos)

Έλεγχος στεγανότητας και βατότητας της οισοφαγονηστιδικής αναστόμωσης (Ευγενική παραχώρηση Dr. V. Penopoulos)

Παρουσία ποικιλομεγέθων στοιβαγμένων θυλακίων αποτελούμενων από κεντροκύτταρα, κεντροβλάστες και λεμφοκυτταρικά διηθήματα με λεμφοεπιθηλιακές βλάβες (Ευγενική παραχώρηση Dr. V. Penopoulos)

Παρουσία ποικιλομεγέθων στοιβαγμένων θυλακίων αποτελούμενων από κεντροκύτταρα, κεντροβλάστες και λεμφοκυτταρικά διηθήματα με λεμφοεπιθηλιακές βλάβες (Ευγενική παραχώρηση Dr. V. Penopoulos)

PET scan. Εμφανής η υπερμεταβολική εστία στον δεξιό μαστό (Ευγενική παραχώρηση Dr. V. Penopoulos)

Παρασκεύασμα τροποποιημένης ριζικής μαστεκτομής και αφαίρεσης μασχαλιαίων λεμφαδένων (Ευγενική παραχώρηση Dr. V. Penopoulos)

Πορογενές καρκίνωμα ανδρικού μαστού. Αιματηρή έκκριση θηλής. Ταχεία βιοψία (Ευγενική παραχώρηση Dr. V. Penopoulos)

Υπερηχογράφημα ανδρικού μαστού. Πορογενές καρκίνωμα (Ευγενική παραχώρηση Dr. V. Penopoulos)
Ψηφιακή μαστογραφία. Θηλώδες καρκίνωμα ανδρικού μαστού (Ευγενική παραχώρηση Dr. V. Penopoulos)

Ψηφιακή μαστογραφία. Πορογενές καρκίνωμα ανδρικού μαστού (Ευγενική παραχώρηση Dr. V. Penopoulos)

Διηθητικό μικροθηλώδες καρκίνωμα ανδρικού μαστού (Ευγενική παραχώρηση Dr. V. Penopoulos)

Έντονη ινώδης μεταβολή στρώματος και λεμφοκυτταρική διήθηση γύρω από τους πόρους του μαστικού αδένα (Ευγενική παραχώρηση Dr. V. Penopoulos)

Εξαιρεθέν οζίδιο σε εγκάρσια τομή. Εμφανής η λευκωπή χροιά του (Ευγενική παραχώρηση Dr. V. Penopoulos)



































